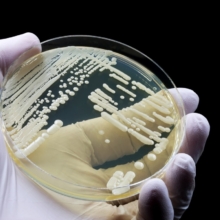
prevenir candida auris en hospitales con nueva herramienta

| |||||||||||||||||||||||||||||||||||||||||||||||||||||||||||||||||||||||||||||||||||||||||||||||||||
TEORIA DEL TODO DE VALDEANDEMAGICO: "En el universo hay vida e inteligencia desde lo infinitamente pequeño hasta lo infinitamente grande, todo crece en modo fractal y está inteligentemente relacionado, luego si conocemos como funciona algo en una escala determinada, podemos cambiar de escala y el conocimiento servirá igual" Phi, causa la gravedad, los agujeros negros, genera la vida, los números, la estructura gramatical…
martes, 3 de marzo de 2026
España prohibirá la venta de bebidas energéticas a menores de 16 años
Suscribirse a:
Comentarios (Atom)